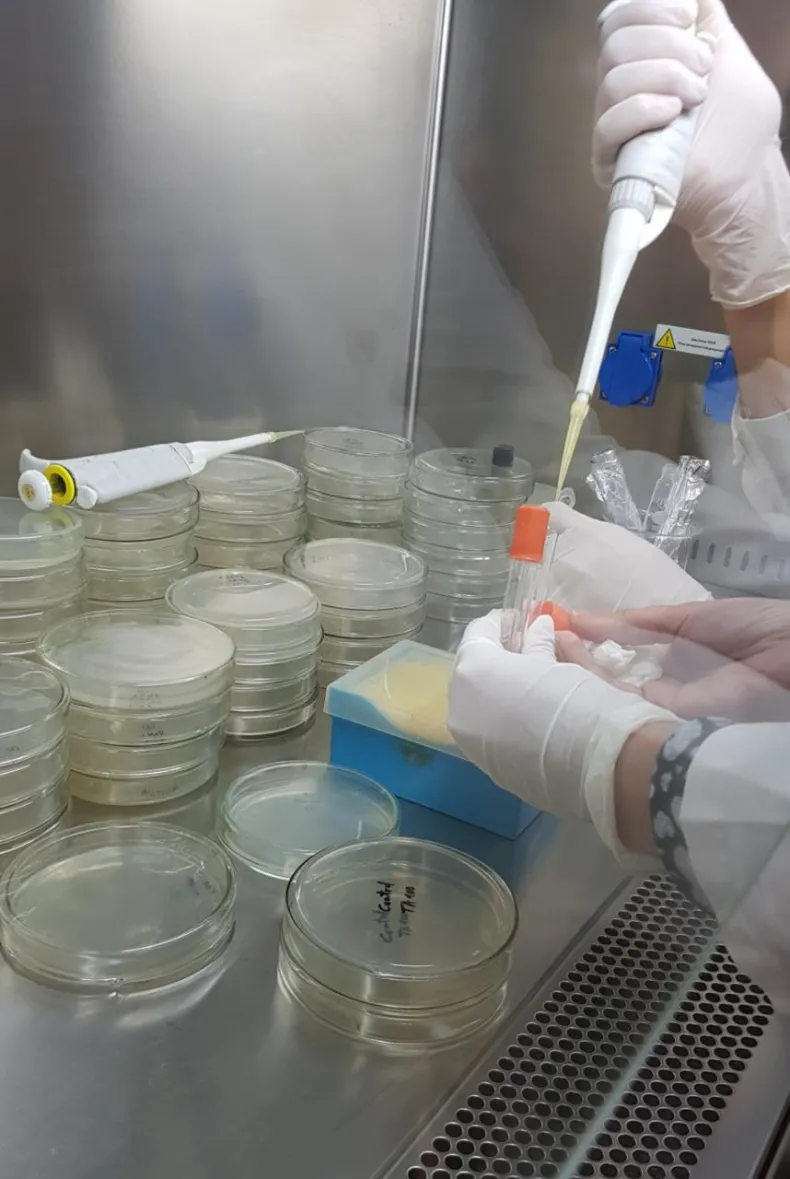

UNCAus investiga sobre la evaluación "in vitro" de Propiedades Farmacológicas y estudios de metales
El Proyecto de investigación de la Universidad Nacional del Chaco Austral (UNCAUS), es dirigido por la doctora, farmacéutica y profesora universitaria por concurso, Libertad Leonor López Tévez.

El Proyecto tiene como finalidad evaluar las propiedades biológicas, seguridad y biodisponibilidad, mediante técnicas in vitro de complejos de metales con ligandos antioxidantes y/o antimicrobianos, que les permitan mostrar su potencial como agentes terapéuticos.
El Proyecto de investigación de la Universidad Nacional del Chaco Austral (UNCAUS), titulado "Evaluación in vitro de Propiedades Farmacológicas y Estudios Teóricos de Complejos de Metales con Ligandos Antioxidantes y/o Antimicrobianos", es dirigido por la doctora, farmacéutica y profesora universitaria por concurso, Libertad Leonor López Tévez, y el doctor y farmacéutico Juan José Martínez Medina, junto a un equipo interdisciplinario de profesionales y alumnos. El mismo comenzó a desarrollarse a partir del mes de enero de 2022 y se prevé su desarrollo hasta el año 2026.
Libertad Leonor López Tévez detalló que: "Puede contribuir a resolver la necesidad social de la gran demanda de agentes antioxidantes y/o antimicrobianos, que constituyen una necesidad clínica urgente y preocupante. Un programa de descubrimiento de fármacos se inicia porque hay una necesidad clínica no satisfecha, como sucede con los agentes antioxidantes y antimicrobianos".
La directora destacó además que: "El proyecto propone un abordaje adecuado del drug discovery, mediante la evaluación in vitro de las propiedades antioxidantes y antimicrobianas de los compuestos de coordinación obtenidos, y atendiendo tres aspectos de la etapa de optimización de moléculas de interés farmacéutico: actividad biológica, seguridad y biodisponibilidad".
Por otro lado, desde la dirección del Proyecto explicaron que se diseñan acciones que se enmarcan en una ciencia interdisciplinaria, la bioinorgánica, donde llevan a cabo la síntesis de compuestos de coordinación con centro metálico, generalmente un catión de compuestos de transición y ligandos orgánicos nitrogenados con propiedades biológicas. Allí la síntesis se lleva a cabo mediante diversos métodos, poniendo en contacto los reactivos metálicos y ligandos hasta encontrar las condiciones adecuadas de solventes, pH y temperatura y proporción de los reactivos. Para confirmar la identidad de los sólidos obtenidos, los trabajadores del proyecto emplearán la espectroscopía vibracional de infrarrojo (FTIR).
Otro de los puntos por estudiar se refiere a la estabilidad de los complejos en solución y se realizan estudios teóricos con programas específicos, por ejemplo, como el Gaussian, con el fin de validar los resultados obtenidos mediante comparación con los datos experimentales. En este sentido, López Tevéz señaló que: "Allí se miden distancias, ángulos, enlaces, cargas, grupos funcionales, con el objeto de predecir algunas propiedades y de fundamentar otras, siempre comparando y validando lo experimental con lo teórico, por supuesto".
"Una vez que el complejo fue caracterizado se inician las determinaciones de las propiedades biológicas, especialmente antimicrobianas (CIM antibacteriana y anticándida, efecto post-antimicrobiano y el posible sinergismo con antibióticos comerciales, como por ejemplo gentamicina, ampicilina) y antioxidantes (Capacidad depuradora del radical DPPH•, Capacidad depuradora del radical ABTS•+, la capacidad antioxidante total usando el coeficiente antioxidante equivalente (TEAC) de trolox y la actividad superóxido dismutasa (SOD) símil)", comentaron.

A su vez, se realizan estudios toxicológicos para definir el perfil de seguridad de la nueva molécula (Test de Ames para el potencial mutagénico de los compuestos en estudio, Test de Artemia salina para la determinación de la toxicidad aguda y Test de Allium cepa para estudiar la genotoxicidad de los compuestos).
López Tévez, indicó que: "A medida que vamos evaluando los resultados parciales podemos ir agregando estudios complementarios, de mecanismo de acción o de factores de virulencia, entre otros. Ninguno de estos ensayos se realiza sobre animales, incluso los estudios de biodisponibilidad se realizan mediante técnicas in vitro".
El Proyecto se realiza en el laboratorio de Química Inorgánica dependiente del Departamento de Ciencias Básicas y Aplicadas, Laboratorio de Química Inorgánica y Laboratorio de Microbiología de la Universidad Nacional del Chaco Austral.
EQUIPO DE TRABAJO
Dra. Farm. López Tévez, Libertad Leonor; Dr. Farm. Martínez, Medina, Juan José; Dra. Ing. Okulik, Nora Beatriz; Licenciada Guevara, Lorena Elizabeth; Farm. Rodríguez, Javier Luis; Farm. Bertiche, Ezequiel Leandro; Farm. Falkievich, Dana Belén, y los estudiantes de la carrera de Farmacia de la Universidad, Martínez Medina, Miguel y Luna, Carla.
